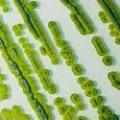

According to official figures in eth United Kingdom, the rate of increase in the number of company administrations reached its highest since the last five years because of continued uncertainty over Brexit and the struggling high street retailers. In the… Read More ›
Day: April 30, 2019
Amazon Could Upend The US Trucking Industry By Undercutting Prices By A Third
According to FreightWaves, market prices are being undercut by as much as a third by the trial version of the online freight-brokerage platform that is being developed by Amazon. This new etch development by the largest e-retailing company of the… Read More ›
UK Scientists Develop World’s First ‘Biosolar Leaf’ To Purify Air
A pioneering research into enhancing the air quality in White City is being undertaken by Imperial College London in collaboration with startup Arborea. According to the Imperial College, this is the first time ever that such a technology for air… Read More ›
Deutsche Bank And Capital One Sued By Trump Because Of House Subpoenas
With the aim of preventing two banks from handing over his financial records to the US Congress, United States President Donald Trump filed legal cases against two banks. The two banks – Deutsche Bank and Capital One, were issued subpoenas… Read More ›
Daimler discontinues sales of Smart mini-cars from U.S., Canada
There is a preference for larger, more efficient EVs that provide more milerange in the U.S. and Canada. Small two-person mini-cars are passe. In a significant development, German automaker Daimler AG stated, it will discontinue the tiny, two-person Smart cars,… Read More ›
European Court of Justice backs EU’s free trade agreement with Canada
In a landmark judgement, the ECJ ruled that provisions of the Comprehensive Economic and Trade Agreement (CETA) are not in breach of EU law. Incidentally, CETA is yet to be full implemented in the EU. On Tuesday, in a significant… Read More ›